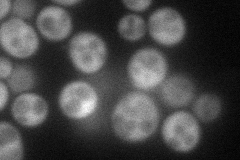
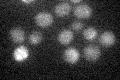

View description
Protein with sequence similarity to Grs1p, which is a glycyl-tRNA synthetase; cannot substitute for Grs1p; possible pseudogene that is expressed at very low levels
Localization:
Intensity:
Fold change:
Significance:
-
C’ GFP library in SD

below threshold13.57 -
N' NOP1pr-GFP in SD
cytosol55.4395 -
N' TEF2pr-mCherry in SD

cytosol0 -
N' NATIVEpr-GFP in SD

below threshold16.0177 -
N' TEF2pr-VC and Cyto-VN in SD

#N/A0 -
C’ GFP library in SD+DTT

cytosol18.961.39No -
C’ GFP library in SD+H2O2

cytosol17.31.27No -
C’ GFP library in Starvation Media
cytosol18.791.38No -
C’ GFP library on the background of Pup2-DaMP

below threshold -
C’ GFP library on the background of CCT mutant

below threshold17.35671.27864No
